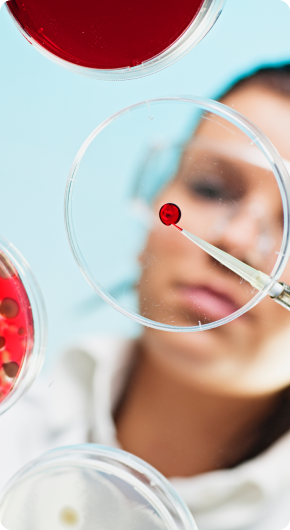

About Praesidia
We are united by a shared commitment to advancing best-in-class medicines for CNS disorders.
Our team of operators, biologists and chemists have extensive experience – from discovery through post-launch development and global approvals. By integrating our collective experiences we are rapidly advancing multiple clinical candidates for psychiatric and neurological disorders.

Praesidia Leadership
Join Us. Make a Difference.
Email Us

Get in Touch
We welcome conversations with potential new partners, investors, and those who believe in our mission.